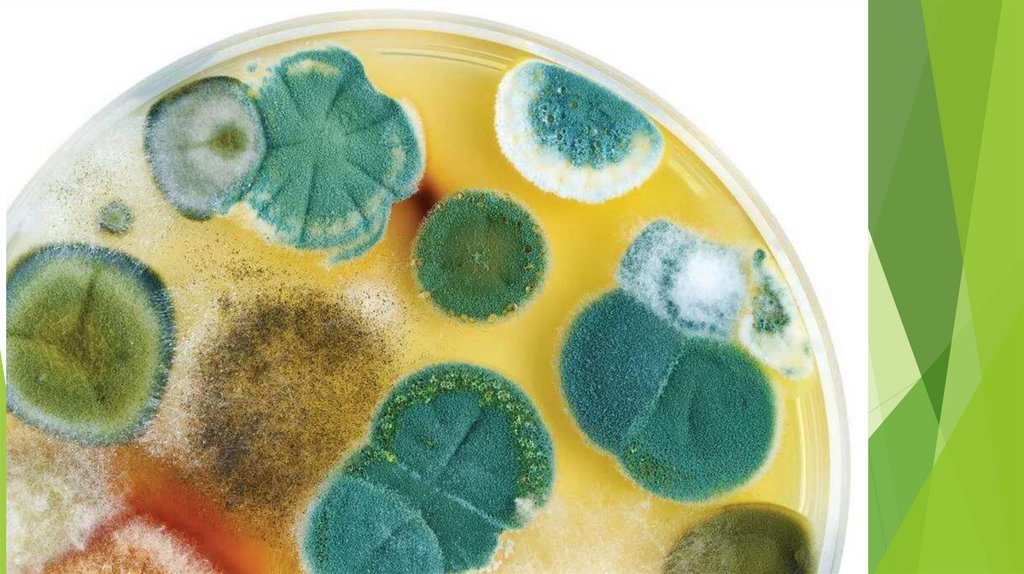

Систематика
1.
2.
3.
4.
5.
6.
7.
8. Разнообразие организмов и их классификация 14.01.2026
9.
10.
Вид- группа особей, сходных по строению, жизнедеятельности,
образу жизни, дающих при скрещивании плодовитое потомство и
населяющих определённую территорию.
11. Виды имеют двойные (бинарные) названия на русском и латинском языках. Бинарную номенклатуру ввёл Карл Линней (18 век)
Например, Берёза белая (лат. Betula alba)род
вид
(существ.) (прилагат.)
род
вид